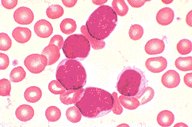

Blood smear from a patient with acute
lymphoblastic leukemia with an associated
Philadelphia chromosome. The lymphoblasts in
this field have a characteristic high nuclear-
cytoplasmic ratio, slightly condensed nuclear
chromatin, and relatively indistinct nucleoli. The
cells illustrated would be classified as an L1,
acute lymphoblastic leukemia.
|